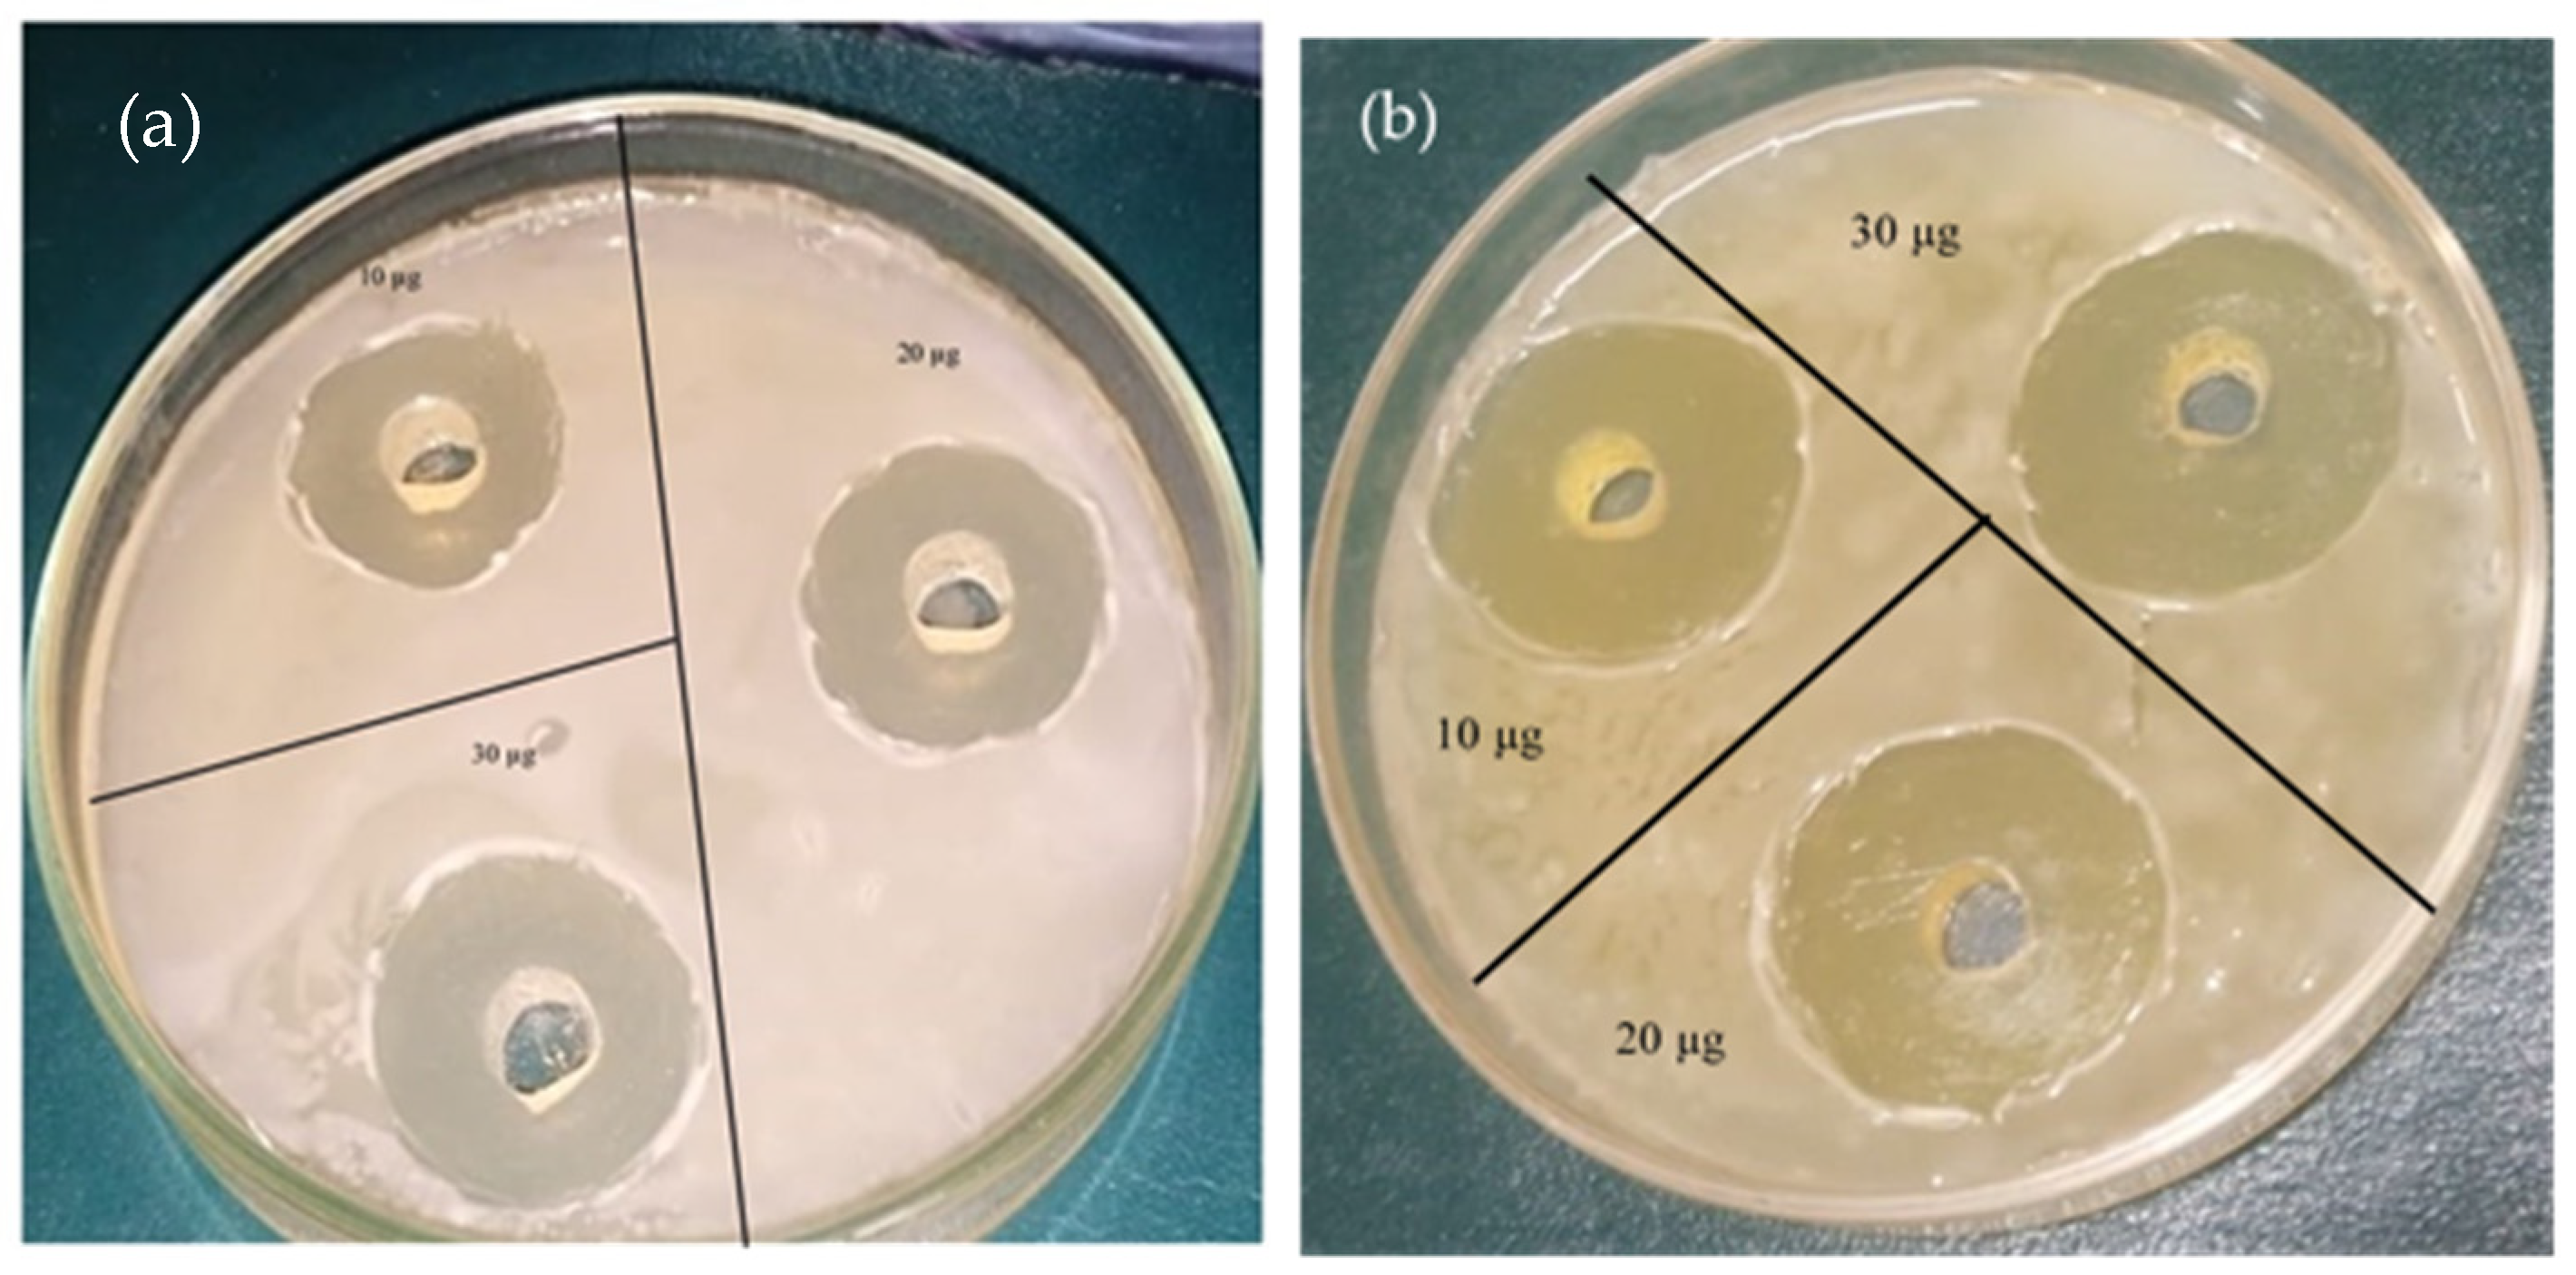

Evaluation of Photocatalytic, Antioxidant, and Antibacterial Efficacy of Almond Oil Capped Zinc Oxide Nanoparticles
Abstract
1. Introduction
2. Materials and Methods
2.1. Extraction of Almond Oil
2.2. Synthesis of ZnO NPs
2.3. Characterizations
Photocatalytic Activity
2.4. Antibacterial Study
2.5. Antioxidant Study
3. Results
3.1. XRD Analysis
3.2. Gaussian Fitting
3.3. Crystallite Size and Dislocation Density
3.4. Morphological Analysis
3.5. EDX Spectra
3.6. Fourier Transform Infrared Spectroscopy (FTIR)
3.7. UV-Vis Spectra
3.8. Photocatalytic Activity
3.8.1. Blank Test
3.8.2. Dye Concentration:
3.8.3. Concentration Effect of ZnO NPs Photocatalysts
3.8.4. Kinetic study
3.8.5. Degradation Mechanism
3.8.6. Reproducibility and Stability
3.9. Antibacterial Activity
3.10. Antioxidant Study
4. Conclusions
Supplementary Materials
Author Contributions
Funding
Institutional Review Board Statement
Informed Consent Statement
Data Availability Statement
Acknowledgments
Conflicts of Interest
References
- Rafique, M.; Tahir, R.; Khalid, N.; Tahir, M.B.; Irshad, M.; Gillani, S.; Usman, A.; Shahzad, K.; Mahmood Ali, A.; Muhammad, S. Hydrothermal synthesis of an efficient and visible light responsive pure and strontium doped zinc oxide nano-hexagonal photocatalysts for photodegradation of Rhodamine B dye. Appl. Nanosci. 2021, 11, 1045–1056. [Google Scholar] [CrossRef]
- Wang, X.; Wang, X.; Meng, A.; Li, Z.; Xing, J. Rapid, continuous, large-scale synthesis of ZnO/Ag hybrid nanoparticles via one-step impinging stream route for efficient photocatalytic and anti-algal applications. Mater. Today Commun. 2022, 30, 103121. [Google Scholar] [CrossRef]
- Khajvand, M.; Mostafazadeh, A.K.; Drogui, P.; Tyagi, R.D.; Brien, E. Greywater characteristics, impacts, treatment, and reclamation using adsorption processes towards the circular economy. Environ. Sci. Pollut. Res. 2022, 29, 10966–11003. [Google Scholar] [CrossRef]
- Gendy, E.A.; Oyekunle, D.T.; Ifthikar, J.; Jawad, A.; Chen, Z. A review on the adsorption mechanism of different organic contaminants by covalent organic framework (COF) from the aquatic environment. Environ. Sci. Pollut. Res. 2022, 29, 32566–32593. [Google Scholar] [CrossRef] [PubMed]
- Sansenya, T.; Masri, N.; Chankhanittha, T.; Senasu, T.; Piriyanon, J.; Mukdasai, S.; Nanan, S. Hydrothermal synthesis of ZnO photocatalyst for detoxification of anionic azo dyes and antibiotic. J. Phys. Chem. Solids 2022, 160, 110353. [Google Scholar] [CrossRef]
- Wang, H.; Li, Z.; Yahyaoui, S.; Hanafy, H.; Seliem, M.K.; Bonilla-Petriciolet, A.; Dotto, G.L.; Sellaoui, L.; Li, Q. Effective adsorption of dyes on an activated carbon prepared from carboxymethyl cellulose: Experiments, characterization and advanced modelling. Chem. Eng. J. 2021, 417, 128116. [Google Scholar] [CrossRef]
- Cheng, H.; Li, X.; Li, T.; Qin, D.; Tang, T.; Li, Y.; Wang, G. Electrospun nanofibers with high specific surface area to prepare modified electrodes for electrochemiluminescence detection of azithromycin. J. Nanomater. 2021, 2021, 9961663. [Google Scholar] [CrossRef]
- Cheng, H.; Zhang, W.; Liu, X.; Tang, T.; Xiong, J. Fabrication of titanium dioxide/carbon fiber (TiO2/CF) composites for removal of methylene blue (MB) from aqueous solution with enhanced photocatalytic activity. J. Chem. 2021, 2021, 9986158. [Google Scholar] [CrossRef]
- Chen, C.; Ma, W.; Zhao, J. Semiconductor-mediated photodegradation of pollutants under visible-light irradiation. Chem. Soc. Rev. 2010, 39, 4206–4219. [Google Scholar] [CrossRef]
- Li, H.; Ding, J.; Cai, S.; Zhang, W.; Zhang, X.; Wu, T.; Wang, C.; Foss, M.; Yang, R. Plasmon-enhanced photocatalytic properties of Au/ZnO nanowires. Appl. Surf. Sci. 2022, 583, 152539. [Google Scholar] [CrossRef]
- Talebian, N.; Nilforoushan, M.R.; Salehi, Z. Effect of heterojunction on photocatalytic properties of multilayered ZnO-based thin films. Ceram. Int. 2012, 38, 4623–4630. [Google Scholar] [CrossRef]
- Liu, H.; Hu, C.; Zhai, H.; Yang, J.; Liu, X.; Jia, H. Fabrication of In2O3/ZnO@ Ag nanowire ternary composites with enhanced visible light photocatalytic activity. RSC Adv. 2017, 7, 37220–37229. [Google Scholar] [CrossRef]
- Zhang, Y.; Cui, W.; An, W.; Liu, L.; Liang, Y.; Zhu, Y. Combination of photoelectrocatalysis and adsorption for removal of bisphenol A over TiO2-graphene hydrogel with 3D network structure. Appl. Catal. B Environ. 2018, 221, 36–46. [Google Scholar] [CrossRef]
- Sahu, K.; Singh, J.; Mohapatra, S. Photocatalytic and catalytic removal of toxic pollutants from water using CuO nanosheets. J. Mater. Sci. Mater. Electron. 2019, 30, 6088–6099. [Google Scholar] [CrossRef]
- Kumar, S.G.; Rao, K.K. Comparison of modification strategies towards enhanced charge carrier separation and photocatalytic degradation activity of metal oxide semiconductors (TiO2, WO3 and ZnO). Appl. Surf. Sci. 2017, 391, 124–148. [Google Scholar] [CrossRef]
- Nayak, P.; Kumar, S.; Sinha, I.; Singh, K.K. ZnO/CuO nanocomposites from recycled printed circuit board: Preparation and photocatalytic properties. Environ. Sci. Pollut. Res. 2019, 26, 16279–16288. [Google Scholar] [CrossRef] [PubMed]
- Xiang, D.; Liu, Z.; Wu, M.; Liu, H.; Zhang, X.; Wang, Z.; Wang, Z.L.; Li, L. Enhanced piezo-photoelectric catalysis with oriented carrier migration in asymmetric Au-ZnO nanorod array. Small 2020, 16, 1907603. [Google Scholar] [CrossRef]
- Wang, S.; Zhu, H.; Tang, W.; Li, P. Propeller-shaped ZnO nanostructures obtained by chemical vapor deposition: Photoluminescence and photocatalytic properties. J. Nanomater. 2012, 2012, 594290. [Google Scholar] [CrossRef]
- Zhou, Z.; Wang, J.; Jhun, C.G. ZnO Nanospheres Fabricated by Mechanochemical Method with Photocatalytic Properties. Catalysts 2021, 11, 572. [Google Scholar] [CrossRef]
- Shen, W.; Li, Z.; Wang, H.; Liu, Y.; Guo, Q.; Zhang, Y. Photocatalytic degradation for methylene blue using zinc oxide prepared by codeposition and sol–gel methods. J. Hazard. Mater. 2008, 152, 172–175. [Google Scholar] [CrossRef]
- Lee, Y.; Fujimoto, T.; Yamanaka, S.; Kuga, Y. Evaluation of photocatalysis of Au supported ZnO prepared by the spray pyrolysis method. Adv. Powder Technol. 2021, 32, 1619–1626. [Google Scholar] [CrossRef]
- Blaskov, V.; Stambolova, I.; Dimitrov, L.; Shipochka, M.; Stoyanova, D.; Eliyas, A. Nanosized Zn2SnO4 powders synthesized by coprecipitation and consecutive hydrothermal treatment in two different alkaline media. Bulg. Chem. Commun. 2018, 50, 58–62. [Google Scholar]
- Pallela, P.N.V.K.; Ruddaraju, L.K.; Veerla, S.C.; Matangi, R.; Kollu, P.; Ummey, S.; Pammi, S. Synergetic antibacterial potential, dye degrading capability and biocompatibility of Asperagus racemosus root assisted ZnO nanoparticles. Mater. Today Commun. 2020, 25, 101574. [Google Scholar] [CrossRef]
- Zhao, L.; Zhang, H.; Xing, Y.; Song, S.; Yu, S.; Shi, W.; Guo, X.; Yang, J.; Lei, Y.; Cao, F. Studies on the magnetism of cobalt ferrite nanocrystals synthesized by hydrothermal method. J. Solid State Chem. 2008, 181, 245–252. [Google Scholar] [CrossRef]
- Tahir, A.; Saeed, A.; Ramzan, I.; Hayat, S.S.; Ahmad, W.; Naeem, S.; Afzal, M.; Mukhtar, A.; Mehmood, T.; Khan, B.S. Mechanism for the formation of magnetite iron oxide nanostructures by Ficus carica dried fruit extract using green synthesis method. Appl. Nanosci. 2021, 11, 1857–1865. [Google Scholar] [CrossRef]
- Lisjak, D.; Ovtar, S.; Drofenik, M. The stability of BaFe12 O19 nanoparticles in polar solvents. J. Mater. Sci. 2011, 46, 2851–2859. [Google Scholar] [CrossRef]
- Gulati, S.; Sachdeva, M.; Bhasin, K. Capping Agents in Nanoparticle Synthesis: Surfactant and Solvent System. In Proceedings of the AIP Conference Proceedings, Bikaner, India, 24–25 November 2017; p. 030214. [Google Scholar]
- Aisida, S.O.; Batool, A.; Khan, F.M.; Rahman, L.; Mahmood, A.; Ahmad, I.; Zhao, T.-k.; Maaza, M.; Ezema, F.I. Calcination induced PEG-Ni-ZnO nanorod composite and its biomedical applications. Mater. Chem. Phys. 2020, 255, 123603. [Google Scholar] [CrossRef]
- Aisida, S.O.; Alnasir, M.H.; Botha, S.; Bashir, A.; Bucher, R.; Ahmad, I.; Zhao, T.-k.; Maaza, M.; Ezema, F.I. The role of polyethylene glycol on the microstructural, magnetic and specific absorption rate in thermoablation properties of Mn-Zn ferrite nanoparticles by sol-gel protocol. Eur. Polym. J. 2020, 132, 109739. [Google Scholar] [CrossRef]
- Aisida, S.O.; Ugwoke, E.; Uwais, A.; Iroegbu, C.; Botha, S.; Ahmad, I.; Maaza, M.; Ezema, F.I. Incubation period induced biogenic synthesis of PEG enhanced Moringa oleifera silver nanocapsules and its antibacterial activity. J. Polym. Res. 2019, 26, 225. [Google Scholar] [CrossRef]
- Rajendran, K.; Sen, S. Effect of capping agent on antimicrobial activity of nanoparticles. Pharm. Lett. 2015, 7, 37–42. [Google Scholar]
- Niu, Z.; Li, Y. Removal and utilization of capping agents in nanocatalysis. Chem. Mater. 2014, 26, 72–83. [Google Scholar] [CrossRef]
- Kim, S.-Y.; Kim, Y.-K.; Jang, Y.-S.; Lee, M.-H. Enhancement of Biofunctionalization by Loading Manuka Oil on TiO2 Nanotubes. Nanomaterials 2022, 12, 569. [Google Scholar] [CrossRef] [PubMed]
- Ouzir, M.; Bernoussi, S.E.; Tabyaoui, M.; Taghzouti, K. Almond oil: A comprehensive review of chemical composition, extraction methods, preservation conditions, potential health benefits, and safety. Compr. Rev. Food Sci. Food Saf. 2021, 20, 3344–3387. [Google Scholar] [CrossRef]
- Cai, J.; Miao, Y.Q.; Yu, B.Z.; Ma, P.; Li, L.; Fan, H.M. Large-scale, facile transfer of oleic acid-stabilized iron oxide nanoparticles to the aqueous phase for biological applications. Langmuir 2017, 33, 1662–1669. [Google Scholar] [CrossRef] [PubMed]
- Salinas, F.; Vardanega, R.; Espinosa-Álvarez, C.; Jimenez, D.; Munoz, W.B.; Ruiz-Domínguez, M.C.; Meireles, M.A.A.; Cerezal-Mezquita, P. Supercritical fluid extraction of chañar (Geoffroea decorticans) almond oil: Global yield, kinetics and oil characterization. J. Supercrit. Fluids 2020, 161, 104824. [Google Scholar] [CrossRef]
- Anand, G.T.; Renuka, D.; Ramesh, R.; Anandaraj, L.; Sundaram, S.J.; Ramalingam, G.; Magdalane, C.M.; Bashir, A.; Maaza, M.; Kaviyarasu, K. Green synthesis of ZnO nanoparticle using Prunus dulcis (Almond Gum) for antimicrobial and supercapacitor applications. Surf. Interfaces 2019, 17, 100376. [Google Scholar] [CrossRef]
- Vijayakumar, S.; Chen, J.; González-Sánchez, Z.I.; Durán-Lara, E.F.; Divya, M.; Shreema, K.; Hadem, H.; Mathammal, R.; Prasannakumar, M.; Vaseeharan, B. Anti-Colon Cancer and Antibiofilm Activities of Green Synthesized ZnO Nanoparticles Using Natural Polysaccharide Almond Gum (Prunus dulcis). J. Clust. Sci. 2021, 34, 165–176. [Google Scholar] [CrossRef]
- Lee, K.M.; Lai, C.W.; Ngai, K.S.; Juan, J.C. Recent developments of zinc oxide based photocatalyst in water treatment technology: A review. Water Res. 2016, 88, 428–448. [Google Scholar] [CrossRef]
- Molaei, P.; Moghadam, F.R. Seed-free synthesis of ZnO nanorods through egg white/glycerol medium for photocatalyst applications. Mater. Today Commun. 2022, 31, 103677. [Google Scholar] [CrossRef]
- Kale, V.; Hunge, Y.; Kamble, S.A.; Deshmukh, M.; Bhoraskar, S.; Mathe, V. Modification of energy level diagram of nano-crystalline ZnO by its composites with ZnWO4 suitable for sunlight assisted photo catalytic activity. Mater. Today Commun. 2021, 26, 102101. [Google Scholar] [CrossRef]
- Lu, Q.; Wei, Z.; Li, C.; Ma, J.; Li, L. Photocatalytic degradation of methyl orange by noble metal Ag modified semiconductor Zn2SnO4. Mater. Sci. Semicond. Process. 2022, 138, 106290. [Google Scholar] [CrossRef]
- Lam, S.-M.; Kee, M.-W.; Sin, J.-C. Influence of PVP surfactant on the morphology and properties of ZnO micro/nanoflowers for dye mixtures and textile wastewater degradation. Mater. Chem. Phys. 2018, 212, 35–43. [Google Scholar] [CrossRef]
- Lv, X.; Du, Y.; Li, Z.; Chen, Z.; Yang, K.; Liu, T.; Zhu, C.; Du, M.; Feng, Y. High photocatalytic property and crystal growth of spindle-like ZnO microparticles synthesized by one-step hydrothermal method. Vacuum 2017, 144, 229–236. [Google Scholar] [CrossRef]
- Guo, B.-L.; Han, P.; Guo, L.-C.; Cao, Y.-Q.; Li, A.-D.; Kong, J.-Z.; Zhai, H.-F.; Wu, D. The antibacterial activity of Ta-doped ZnO nanoparticles. Nanoscale Res. Lett. 2015, 10, 336. [Google Scholar] [CrossRef] [PubMed]
- Kaya, Y.; Erten, T.; Vurmaz, M.; İspirli, H.; Şimşek, Ö.; Dertli, E. Comparison of the probiotic characteristics of Lactic Acid Bacteria (LAB) isolated from sourdough and infant feces. Food Biosci. 2022, 47, 101722. [Google Scholar] [CrossRef]
- Moschonas, G.; Lianou, A.; Nychas, G.-J.E.; Panagou, E.Z. Spoilage potential of Bacillus subtilis in a neutral-pH dairy dessert. Food Microbiol. 2021, 95, 103715. [Google Scholar] [CrossRef]
- Esmailzadeh, H.; Sangpour, P.; Shahraz, F.; Hejazi, J.; Khaksar, R. Effect of nanocomposite packaging containing ZnO on growth of Bacillus subtilis and Enterobacter aerogenes. Mater. Sci. Eng. C 2016, 58, 1058–1063. [Google Scholar] [CrossRef] [PubMed]
- Alangari, A.; Alqahtani, M.S.; Mateen, A.; Kalam, M.A.; Alshememry, A.; Ali, R.; Kazi, M.; AlGhamdi, K.M.; Syed, R. Iron oxide nanoparticles: Preparation, characterization, and assessment of antimicrobial and anticancer activity. Adsorpt. Sci. Technol. 2022, 2022, 1562051. [Google Scholar] [CrossRef]
- El-Seedi, H.R.; El-Shabasy, R.M.; Khalifa, S.A.; Saeed, A.; Shah, A.; Shah, R.; Iftikhar, F.J.; Abdel-Daim, M.M.; Omri, A.; Hajrahand, N.H. Metal nanoparticles fabricated by green chemistry using natural extracts: Biosynthesis, mechanisms, and applications. RSC Adv. 2019, 9, 24539–24559. [Google Scholar] [CrossRef] [PubMed]
- Mohd Yusof, H.; Mohamad, R.; Zaidan, U.H.; Rahman, A. Microbial synthesis of zinc oxide nanoparticles and their potential application as an antimicrobial agent and a feed supplement in animal industry: A review. J. Anim. Sci. Biotechnol. 2019, 10, 57. [Google Scholar] [CrossRef]
- Khan, I.; Khan, I.; Usman, M.; Imran, M.; Saeed, K. Nanoclay-mediated photocatalytic activity enhancement of copper oxide nanoparticles for enhanced methyl orange photodegradation. J. Mater. Sci. Mater. Electron. 2020, 31, 8971–8985. [Google Scholar] [CrossRef]
- Zhang, Y.; Mu, J. Controllable synthesis of flower-and rod-like ZnO nanostructures by simply tuning the ratio of sodium hydroxide to zinc acetate. Nanotechnology 2007, 18, 075606. [Google Scholar] [CrossRef] [PubMed]
- Osman, D.A.M.; Mustafa, M.A. Synthesis and characterization of zinc oxide nanoparticles using zinc acetate dihydrate and sodium hydroxide. J. Nanosci. Nanoeng. 2015, 1, 248–251. [Google Scholar]
- Siriphongsapak, N.; Denchitcharoen, S.; Limsuwan, P. Hydrothermal growth of ZnO nanostructures using sodium hydroxide as a source of hydroxide ion. Mater. Today Proc. 2020, 23, 712–719. [Google Scholar] [CrossRef]
- Dejene, F.; Ali, A.; Swart, H.; Botha, R.; Roro, K.; Coetsee, L.; Biggs, M. Optical properties of ZnO nanoparticles synthesized by varying the sodium hydroxide to zinc acetate molar ratios using a Sol-Gel process. Open Phys. 2011, 9, 1321–1326. [Google Scholar] [CrossRef]
- Akhil, K.; Jayakumar, J.; Gayathri, G.; Khan, S.S. Effect of various capping agents on photocatalytic, antibacterial and antibiofilm activities of ZnO nanoparticles. J. Photochem. Photobiol. B Biol. 2016, 160, 32–42. [Google Scholar] [CrossRef]
- Gregory, N. Elements of X-Ray Diffraction. J. Am. Chem. Soc. 1957, 79, 1773–1774. [Google Scholar] [CrossRef]
- Gan, Y.X.; Jayatissa, A.H.; Yu, Z.; Chen, X.; Li, M. Hydrothermal synthesis of nanomaterials. J. Nanomater. 2020, 2020, 8917013. [Google Scholar] [CrossRef]
- Banerjee, S.; Gopal, J.; Muraleedharan, P.; Tyagi, A.K.; Raj, B. Physics and chemistry of photocatalytic titanium dioxide: Visualization of bactericidal activity using atomic force microscopy. Curr. Sci. 2006, 90, 1378–1383. [Google Scholar]
- Shaban, M.; Zayed, M.; Hamdy, H. Nanostructured ZnO thin films for self-cleaning applications. RSC Adv. 2017, 7, 617–631. [Google Scholar] [CrossRef]
- Kumar, S.; Nehra, M.; Kedia, D.; Dilbaghi, N.; Tankeshwar, K.; Kim, K.-H. Nanotechnology-based biomaterials for orthopaedic applications: Recent advances and future prospects. Mater. Sci. Eng. C 2020, 106, 110154. [Google Scholar] [CrossRef]
- Goujon, G.; Baldim, V.; Roques, C.; Bia, N.; Seguin, J.; Palmier, B.; Graillot, A.; Loubat, C.; Mignet, N.; Margaill, I. Antioxidant activity and toxicity study of cerium oxide nanoparticles stabilized with innovative functional copolymers. Adv. Healthc. Mater. 2021, 10, 2100059. [Google Scholar] [CrossRef] [PubMed]
- Shen, X.; Shao, H.; Liu, Y.; Zhai, Y. Synthesis and photocatalytic performance of ZnO with flower-like structure from zinc oxide ore. J. Mater. Sci. Technol. 2020, 51, 1–7. [Google Scholar] [CrossRef]
- Sowri Babu, K.; Ramachandra Reddy, A.; Sujatha, C.; Venugopal Reddy, K.; Mallika, A. Synthesis and optical characterization of porous ZnO. J. Adv. Ceram. 2013, 2, 260–265. [Google Scholar] [CrossRef]
- He, C.; Sasaki, T.; Usui, H.; Shimizu, Y.; Koshizaki, N. Fabrication of ZnO nanoparticles by pulsed laser ablation in aqueous media and pH-dependent particle size: An approach to study the mechanism of enhanced green photoluminescence. J. Photochem. Photobiol. A Chem. 2007, 191, 66–73. [Google Scholar] [CrossRef]
- Kaur, M.; Kaur, P.; Kaur, G.; Dev, K.; Negi, P.; Sharma, R. Structural, morphological and optical properties of Eu-N co-doped zinc oxide nanoparticles synthesized using co-precipitation technique. Vacuum 2018, 155, 689–695. [Google Scholar] [CrossRef]
- Aslinjensipriya, A.; Narmadha, S.; Deepapriya, S.; John, D.R.; Grace, I.S.; Reena, R.S.; Chamundeeswari, A.; Jose, M.; Jerome, D.S. Synthesis and Characterization of ZnO Nanoparticles by Novel Sol Gel Technique. In Proceedings of the AIP Conference Proceedings, Mangalore, India, 19–21 September 2019; p. 070013. [Google Scholar]
- Bashir, M.; Majid, F.; Akram, S.; Ali, A.; Abdelmohsen, S.A. Biodegradation of gelatin stabilized tetragonal zirconia synthesized by microwave assisted sol-gel method. J. Mech. Behav. Biomed. Mater. 2022, 127, 105070. [Google Scholar] [CrossRef]
- Bukhari, S.B.; Imran, M.; Bashir, M.; Riaz, S.; Naseem, S. Room temperature stabilized TiO2 doped ZrO2 thin films for teeth coatings—A sol-gel approach. J. Alloys Compd. 2018, 767, 1238–1252. [Google Scholar] [CrossRef]
- Verma, N.; Bhatia, S.; Bedi, R. Role of pH on electrical, optical and photocatalytic properties of ZnO based nanoparticles. J. Mater. Sci. Mater. Electron. 2017, 28, 9788–9797. [Google Scholar] [CrossRef]
- Amsha, A.A.A. Synthesis and Characterization of Nanosized Metal Oxides. 2015. Available online: http://dspace.alazhar.edu.ps/xmlui/handle/123456789/766 (accessed on 12 July 2023).
- Barkat, F.; Afzal, M.; Khan, B.S.; Saeed, A.; Bashir, M.; Mukhtar, A.; Mehmood, T.; Wu, K. Formation Mechanism and Lattice Parameter Investigation for Copper-Substituted Cobalt Ferrites from Zingiber officinale and Elettaria cardamom Seed Extracts Using Biogenic Route. Materials 2022, 15, 4374. [Google Scholar] [CrossRef]
- Pearton, S.; Norton, D.; Ip, K.; Heo, Y.; Steiner, T. Recent progress in processing and properties of ZnO. Prog. Mater. Sci. 2005, 50, 293–340. [Google Scholar] [CrossRef]
- Yadav, R.S.; Mishra, P.; Pandey, A.C. Growth mechanism and optical property of ZnO nanoparticles synthesized by sonochemical method. Ultrason. Sonochemistry 2008, 15, 863–868. [Google Scholar] [CrossRef]
- Murugesan, S.; Sasibabu, V.; Jegadeesan, G.B.; Venkatachalam, P. Photocatalytic degradation of Reactive Black dye using ZnO–CeO2 nanocomposites. Environ. Sci. Pollut. Res. 2022, 30, 42713–42727. [Google Scholar] [CrossRef] [PubMed]
- Sharma, M.; Sondhi, H.; Krishna, R.; Srivastava, S.K.; Rajput, P.; Nigam, S.; Joshi, M. Assessment of GO/ZnO nanocomposite for solar-assisted photocatalytic degradation of industrial dye and textile effluent. Environ. Sci. Pollut. Res. 2020, 27, 32076–32087. [Google Scholar] [CrossRef] [PubMed]
- Vishwanathan, S.; Das, S. Glucose-mediated one-pot hydrothermal synthesis of hollow magnesium oxide-zinc oxide (MgO-ZnO) microspheres with enhanced natural sunlight photocatalytic activity. Environ. Sci. Pollut. Res. 2022, 2022, 6484573. [Google Scholar] [CrossRef]
- Yuan, D.; Liu, G.; Qi, F.; Wang, J.; Kou, Y.; Cui, Y.; Bai, M.; Li, X. Kinetic study on degradation of micro-organics by different UV-based advanced oxidation processes in EfOM matrix. Environ. Sci. Pollut. Res. 2022, 29, 45314–45327. [Google Scholar] [CrossRef]
- Babel, S.; Sekartaji, P.A.; Sudrajat, H. ZnO nanoparticles for photodegradation of humic acid in water. Environ. Sci. Pollut. Res. 2021, 28, 31163–31173. [Google Scholar] [CrossRef] [PubMed]
- Garg, R.; Gupta, R.; Singh, N.; Bansal, A. Characterization and performance evaluation of synthesized ZnO nanoflowers, nanorods, and their hybrid nanocomposites with graphene oxide for degradation of Orange G. Environ. Sci. Pollut. Res. 2021, 28, 57009–57029. [Google Scholar] [CrossRef]
- Chan, Y.Y.; Pang, Y.L.; Lim, S.; Lai, C.W.; Abdullah, A.Z.; Chong, W.C. Biosynthesized Fe-and Ag-doped ZnO nanoparticles using aqueous extract of Clitoria ternatea Linn for enhancement of sonocatalytic degradation of Congo red. Environ. Sci. Pollut. Res. 2020, 27, 34675–34691. [Google Scholar] [CrossRef]
- Baruah, S.; Dutta, J. Nanotechnology applications in pollution sensing and degradation in agriculture: A review. Environ. Chem. Lett. 2009, 7, 191–204. [Google Scholar] [CrossRef]
- Bhatia, S.; Verma, N.; Mahajan, A.; Bedi, R. Characterization of ZnO films based sensors prepared by different techniques. Proc. Appl. Mech. Mater. 2015, 772, 50–54. [Google Scholar]
- Rakhshaei, R.; Namazi, H.; Hamishehkar, H.; Kafil, H.S.; Salehi, R. In situ synthesized chitosan–gelatin/ZnO nanocomposite scaffold with drug delivery properties: Higher antibacterial and lower cytotoxicity effects. J. Appl. Polym. Sci. 2019, 136, 47590. [Google Scholar] [CrossRef]
- Luévano-Hipólito, E.; Torres-Martínez, L. Sonochemical synthesis of ZnO nanoparticles and its use as photocatalyst in H2 generation. Mater. Sci. Eng. B 2017, 226, 223–233. [Google Scholar] [CrossRef]
- Applerot, G.; Lellouche, J.; Perkas, N.; Nitzan, Y.; Gedanken, A.; Banin, E. ZnO nanoparticle-coated surfaces inhibit bacterial biofilm formation and increase antibiotic susceptibility. RSC Adv. 2012, 2, 2314–2321. [Google Scholar] [CrossRef]
- Sanitnon, P.; Chiarakorn, S.; Chawengkijwanich, C.; Chuangchote, S.; Pongprayoon, T. Synergistic effects of zirconium and silver co-dopants in TiO2 nanoparticles for photocatalytic degradation of an organic dye and antibacterial activity. J. Aust. Ceram. Soc. 2020, 56, 579–590. [Google Scholar] [CrossRef]
- Zhang, L.; Jiang, Y.; Ding, Y.; Daskalakis, N.; Jeuken, L.; Povey, M.; O’neill, A.J.; York, D.W. Mechanistic investigation into antibacterial behaviour of suspensions of ZnO nanoparticles against E. coli. J. Nanoparticle Res. 2010, 12, 1625–1636. [Google Scholar] [CrossRef]
- Batool, M.; Khurshid, S.; Qureshi, Z.; Daoush, W.M. Adsorption, antimicrobial and wound healing activities of biosynthesised zinc oxide nanoparticles. Chem. Pap. 2021, 75, 893–907. [Google Scholar] [CrossRef]
- Jiang, Y.; Zhang, L.; Wen, D.; Ding, Y. Role of physical and chemical interactions in the antibacterial behavior of ZnO nanoparticles against E. coli. Mater. Sci. Eng. C 2016, 69, 1361–1366. [Google Scholar] [CrossRef]
- Da Silva, B.L.; Caetano, B.L.; Chiari-Andréo, B.G.; Pietro, R.C.L.R.; Chiavacci, L.A. Increased antibacterial activity of ZnO nanoparticles: Influence of size and surface modification. Colloids Surf. B Biointerfaces 2019, 177, 440–447. [Google Scholar] [CrossRef]
- Bandekar, P.P.; Roopnarine, K.A.; Parekh, V.J.; Mitchell, T.R.; Novak, M.J.; Sinden, R.R. Antimicrobial activity of tryptanthrins in Escherichia coli. J. Med. Chem. 2010, 53, 3558–3565. [Google Scholar] [CrossRef]
- Fiedot, M.; Maliszewska, I.; Rac-Rumijowska, O.; Suchorska-Woźniak, P.; Lewińska, A.; Teterycz, H. The relationship between the mechanism of zinc oxide crystallization and its antimicrobial properties for the surface modification of surgical meshes. Materials 2017, 10, 353. [Google Scholar] [CrossRef] [PubMed]
- Awan, S.S.; Khan, R.T.; Mehmood, A.; Hafeez, M.; Abass, S.R.; Nazir, M.; Raffi, M. Ailanthus altissima leaf extract mediated green production of zinc oxide (ZnO) nanoparticles for antibacterial and antioxidant activity. Saudi J. Biol. Sci. 2023, 30, 103487. [Google Scholar] [CrossRef] [PubMed]

| Molar Ratio | a (Å) | c (Å) |
|---|---|---|
| 0.5:1 | 3.27 | 5.69 |
| 0.75:1 | 3.27 | 5.64 |
| 1:1 | 3.26 | 5.63 |
| 1.25:1 | 3.26 | 5.64 |
| 1.5:1 | 3.36 | 5.65 |
| Catalyst | Surfactant | Dopant | Dye Concentration (ppm) | Degradation Time (min) | Photo Degradation (%) | References |
|---|---|---|---|---|---|---|
| ZnO | Pithecellobium dulce peel | - | 50 | ~63 | [39] | |
| ZnO | Ag-r-GO | 20 | 120 | 95.0 | [40] | |
| ZnO | 10 | 50 | 80.8 | [41] | ||
| ZnO | Urea | 10 | 30 | 92 | [42] | |
| ZnO | - | 25 | 90 | 93 | Present Study |
| Microorganism | 1.5:1 | Ciprofloxacin | ||
|---|---|---|---|---|
| IZ 1 | MIC 2 | IZ 1 | MIC 2 | |
| E. coli | 29.0 ± 1.03 | 0.30 ± 0.011 | 28.1 ± 1.03 | 6.0 × 10−3 |
| Pseudomonas aeruginosa | 32.1 ± 1.13 | 0.26 ± 0.011 | 33.0 ± 1.63 | 8.0 × 10−3 |
| Concentration (µg/mL) | ZnO NPs (Cycle 1) 4 | ZnO NPs (Cycle 2) 5 | ZnO NPs (Cycle 3) 6 | Control | Mean 3 | Standard Deviation 3 |
|---|---|---|---|---|---|---|
| 10 | 9 | 9.1 | 9.23 | 12 | 9.11 | 0.09 |
| 20 | 24 | 24.2 | 24.12 | 25 | 24.11 | 0.08 |
| 50 | 49 | 49.1 | 48.59 | 50 | 48.90 | 0.22 |
| 100 | 65 | 65.1 | 65.1 | 78 | 65.07 | 0.05 |
| 150 | 88 | 87.89 | 87.88 | 88 | 87.92 | 0.05 |
| 200 | 94 | 94.1 | 93.73 | 96 | 93.94 | 0.16 |
Disclaimer/Publisher’s Note: The statements, opinions and data contained in all publications are solely those of the individual author(s) and contributor(s) and not of MDPI and/or the editor(s). MDPI and/or the editor(s) disclaim responsibility for any injury to people or property resulting from any ideas, methods, instructions or products referred to in the content. |
© 2023 by the authors. Licensee MDPI, Basel, Switzerland. This article is an open access article distributed under the terms and conditions of the Creative Commons Attribution (CC BY) license (https://creativecommons.org/licenses/by/4.0/).
Share and Cite
Ramzan, I.; Bashir, M.; Saeed, A.; Khan, B.S.; Shaik, M.R.; Khan, M.; Shaik, B.; Khan, M. Evaluation of Photocatalytic, Antioxidant, and Antibacterial Efficacy of Almond Oil Capped Zinc Oxide Nanoparticles. Materials 2023, 16, 5011. https://doi.org/10.3390/ma16145011
Ramzan I, Bashir M, Saeed A, Khan BS, Shaik MR, Khan M, Shaik B, Khan M. Evaluation of Photocatalytic, Antioxidant, and Antibacterial Efficacy of Almond Oil Capped Zinc Oxide Nanoparticles. Materials. 2023; 16(14):5011. https://doi.org/10.3390/ma16145011
Chicago/Turabian StyleRamzan, Iqra, Mahwish Bashir, Adnan Saeed, Babar Shahzad Khan, Mohammed Rafi Shaik, Merajuddin Khan, Baji Shaik, and Mujeeb Khan. 2023. "Evaluation of Photocatalytic, Antioxidant, and Antibacterial Efficacy of Almond Oil Capped Zinc Oxide Nanoparticles" Materials 16, no. 14: 5011. https://doi.org/10.3390/ma16145011
APA StyleRamzan, I., Bashir, M., Saeed, A., Khan, B. S., Shaik, M. R., Khan, M., Shaik, B., & Khan, M. (2023). Evaluation of Photocatalytic, Antioxidant, and Antibacterial Efficacy of Almond Oil Capped Zinc Oxide Nanoparticles. Materials, 16(14), 5011. https://doi.org/10.3390/ma16145011

